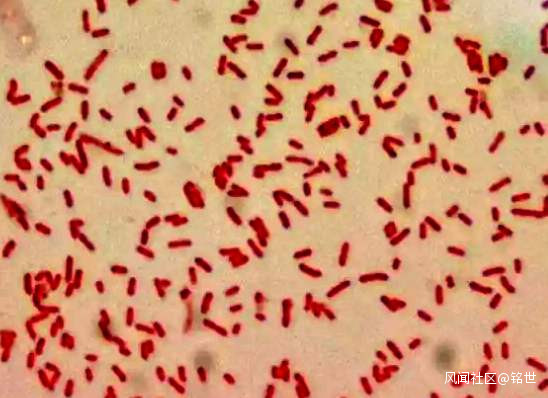

科幻小説《人體殺陣》-02章 南上加南 006節_風聞
铭世-复兴2020-03-21 15:31
作者:銘世
凌晨的微風也帶着醉意。
赫伊裏渴望的神情:“十萬磅!?”(埃及物價比較便宜,1埃及磅=0.44人民幣,10萬埃及磅=4.4萬人民幣。)
被自己的貧窮限制了想象力,安道心裏笑了。
安道:“二十萬!我和布爾汗大哥一人十萬。”
赫伊裏:“在哪兒?”
安道:“在莫桑比克上利戈尼亞市東郊的一棵大樹下面埋着。”
赫伊裏:“要不這樣,貴客,我送你去,咱倆平分,不然放那兒時間長就爛了,你也有損失。”
安道眼睛一亮:“行啊!可是我們怎麼去呢?”
赫伊裏:“布爾汗哥哥的潛艇在我手裏,隨時可以出發!”
安道:“現在行嗎?”
赫伊裏:“現在走比白天容易!”
安道:“要不……”
赫伊裏:“走,法瓦茲,你快去收拾東西,把所有的皮塔(Pita)都帶上看夠不夠!我把這些羊肉全烤了咱們路上吃。”
安道:“好象不一定夠吧?”
赫伊裏:“沒事,海上還能捕魚吃!(看兒子法瓦茲沒動地方)你幹什麼呢!快點!”
法瓦茲:“明天我約好了白薩木去釣魚了。”
赫伊裏:“什麼釣魚!你就是想進城去瞎跑,快點!”
赫伊裏站起來把法瓦茲攆進屋裏。法瓦茲在屋裏拉住赫伊裏。
法瓦茲:“爸,布爾汗大伯怎麼會把錢埋在莫桑比克呢?”
赫伊裏醉意:“他那錢來路不明,不藏怎麼花!”
赫伊裏又出來,賣力地烤起卡巴布。
安道心裏覺得有趣:貪慾矇蔽了赫伊裏的雙眼。象這樣的聰明人都喜歡賺快錢,爆發力十足,而且相信運氣,説幹就幹,過幾天爆發力一過就又趴窩改主意了。所以必須要快。象埃及這樣熱愛神話故事的國家,喜歡聽故事的人很多。
為了逃命,編吧。
夜色深沉,凌晨三點,三個人出發了。
安道已經跟他們説好,目的地是莫桑比克海濱城市利烏波,然後登陸向西去上利戈尼亞市東郊。

凌晨的村子萬籟俱寂,沒人注意到布爾汗的老宅子裏發生了什麼,赫伊裏一行三人經過兩個多小時的路程來到海邊。
老布爾汗的微型潛艇,隱藏在草木掩映之間的小水灣裏,潛艇上書綠色阿拉伯大字“海神”( بوسيدون )!這艘通體黑色微潛長15米,直徑4米,內部可以活動空間長10米,高2米。視物靠的是潛艇周身8個可旋轉攝像頭連接到駕駛位的監視器。
赫伊裏把小車藏好,指紋開鎖,大家進了潛艇。
潛艇裏,前部是駕駛位置,後面是倉庫,有兩個帶安全帶的活動壁椅。那裏放着赫伊裏的各種魚具、攪在一塊的廚具和毯子。散發着濃重的魚腥味。一個應急坐便器,上面扣着蓋子。
更無二話,一行人馬上出發,赫伊裏設定自動航行,深度,路線,航速,出發地點——阿萊姆港南部無人區,目標——莫桑比克海濱城市利烏波。
赫伊裏帶着醉意與按捺不住的喜悦大喊:“海神號,啓航!”
船啓動時,時間已經是清晨6:30,天邊矇矇亮,再過20多分鐘就日出了。

三個人剛剛結識,折騰了一晚上,就踏上3200海里(3200海里=5926.4公里,1節=1海里=1.852公里)的航程,不可謂不是行動派。
一夜海吹神聊的亢奮,掏空了三人,他們胡亂為自己拉一張毯子,相繼一字排開,在海神號船艙裏迅速地睡着了。
3200海里,航速42節(42節=77.784公里/小時),76.2小時左右可以到達。
8個多小時後,赫伊裏被法瓦茲搖醒,兒子要到海面去小便。赫伊裏告訴他用坐便器。法瓦茲不想,因為那樣氣味會瀰漫整個船艙,他以前坐海神號時這樣做過,被布爾汗大伯取笑能聞到皮塔(Pita)味,成為一路的談資,現在他還記憶猶新。
赫伊裏轉身繼續睡了,法瓦茲年青睡不着,為了自己的尊嚴憋着,不時地原地轉圈。
法瓦茲只感到壓力越來越大。他只認為自己本來應該跟小夥伴一起在阿萊姆港看長相各異的外國遊客,到處閒逛,結果被扯進這樣的混帳事,現在連小便都不行。
又過了兩個多小時,渾身不自在的法瓦茲好象突然受到什麼提示一般,目光變得十分堅毅,他果敢地越過父親,跳到坐便器上,剛一坐好,坐便器裏的咆哮聲就響徹海神號,好象在怒斥着兩個多小時的不公待遇!去他的尊嚴吧!保命要緊!
赫伊裏罵罵咧咧地坐起來,想盡量遠離他親愛的兒子。
赫伊裏:“你不是小便嗎!”
法瓦茲:“那是兩個小時以前。”
不一會兒,真正的災難開始了,安道也被鼻子弄醒了,無法言喻。好象還有昨天晚上的卡巴布味,災難。
重獲新生的法瓦茲是最輕鬆的那個人,他坐在地上非常愜意,空氣中的味道體現着他強大的氣場。
赫伊裏也需要解決下,當他一揭開坐便器的蓋子,就迅速地蓋上了,險些交出昨天的晚餐。
安道:“現在是冬天,天黑了。”
這個時候的日出日落間只有10小時19分鐘左右,加上日出前日落後有天光的40多分鐘,大約11個小時,船啓動時6點30天矇矇亮,三人在船裏折騰了快一個小時,又睡了10個多小時,現在天應該是剛黑。
有理!立刻上浮!海神號一露出水面,赫伊裏和安道就上去解決內務,通風功能一併開啓。

海神號熄燈上浮,這裏是沙特阿拉伯和蘇丹之間的紅海海域,寬300公里,而海神號在雙岸中線高出海面1米繼續航行,藍色的海浪拍打在海神號頭部,擊起一串串白色浪花,夜色中潛艇很不起眼。周圍一眼看出去,沒有任何船隻,陣陣靜謐的微風襲來,阿拉伯彎刀般的月亮似要收割漫天星斗,一掃船艙的壓抑窒息。
一半是海水,一半是夜空,中間即將隱沒的紅霞,如神之巨力焊海天一處,安道為之動容。赫伊裏則全然沒見一般,從小耳濡目染,還想他付出多少激動呢。
紅海是藍的,其名遡義有諸如季節性的紅色藻類這樣的解釋,然而古代西亞民族用黑表示北方,紅表示南方,那麼紅海就是“南方的海”。這與中國五行一致,南朱雀紅色,北玄武黑色。
安道拋下船尾的赫伊裏走向船頭,臨風遠眺,頭髮肆意地躍動,就如同思緒。
十幾公里外的海平線天海相接。但這條線根本不存在。多少人曾向着這十幾公里外的海平線駛去,以為在那裏能駛入天空,終究發現離天萬仞,海平線永遠在十幾公里以外。人生莫不如此,很多美妙事物無法獲得,這種美妙存在只是證明追求的極限,不然憧憬之意義何在?也許憧憬的時候,我們就已經獲得了獲得的極限。
安道覺得這似乎就是自己的人生,他來埃及是為追求恬適,從前的人生懸於生死一線。然而埃及的恬適舒展,又因為那箱子極速收斂於生死一線。
難道,註定沒有安寧嗎?
下面的法瓦茲還在想要不要上去透氣,上面傳來赫伊裏的聲音。
赫伊裏:“你趕快把坐便刷了!有刷子!”
法瓦茲:“找不到!”
父親赫伊裏:“你最好找到,這樣你就可以不弄髒雙手。”
兒子法瓦茲想了想這話,明白其中深刻的含義。壓力產生了動力,赫伊裏在雜物裏找到刷子,拎着應急坐便上來,看到船頭觀海的安道,和船尾蹲着的父親赫伊裏,他就在潛艇中段開刷坐便器。潛艇不怕髒,一下沉,紅海就會細緻地讓一切恢復清潔。
法瓦茲“哇——”地一聲驚叫傳來。
月光下安道看到,是海浪打在坐便器裏濺到法瓦茲,這孩子驚慌中把坐便器扔了上來,自己卻翻下潛艇!這詭譎的行為!30節的航速很危險,艇尾的赫伊裏眼疾手快,拉住了劈波斬浪的法瓦茲,安全後法瓦茲瘋狂地用海水洗刷自己。父親赫伊裏哈哈大笑。
赫伊裏笑夠了:“好了,快點下去。”
由於擔心被各國海警當成可疑船隻扣留,三個人又進了船艙關門下潛繼續行進。船艙裏的空氣也正常了。
下面的500海里(926公里)會經過六個國家,包括現在經過的沙特,蘇丹,厄立特里亞,也門,吉布提,索馬里,各國海警出沒在海濤之中,沒人想去“協助調查”,一扣幾十天,麻煩可大了。
濕漉漉的法瓦茲悶悶不樂,父親赫伊裏慈祥地看着他。
赫伊裏:“沒事的,我以前刷坐便的時候,也跟你一樣,崩了一身,掉到水裏,所有人都有過。”
法瓦茲心情好很多:“是嗎?”
父親赫伊裏突然大笑:“怎麼可能呢?你以為我象你一樣笨嗎?”
赫伊裏還得意地看了安道一眼,安道也忍不住笑了。
父親赫伊裏:“但是你還是值得表揚的。”
法瓦茲眼角偷瞄,想知道為什麼。
赫伊裏:“你救了坐便器!”
赫伊裏又爆發出一陣震盪波似的笑聲。
法瓦茲不理赫伊裏。
赫伊裏笑夠了沒事做,就把信號接收器施放到水面,還告訴安道可以上網了。
赫伊裏開始翻看手機,看新聞可以讓人感覺與世界是一體的。
赫伊裏:“哎,美國又開始鬧了。”
安道和赫伊裏對視一眼,他看赫伊裏手機上的全息立體圖像。裏面有“美國懷疑”“埃及調查”“尚未確定”等字樣。
安道也拿出手機。這才幾天,難道?埃博拉也沒這麼快吧?但那車裏的其他七個箱子怎麼解釋?是要送到哪裏的,之前呢,或許亞歷山大並不是第一個收到箱子甚至是最後一個。問題複雜了。
安道也打開自己手機,隨着翻看網頁,發現“開羅醫院系統感受壓力”“遊客在曼蘇拉突然倒下被送醫”“宰加濟格醫院醫護人員病倒”“塞得港街頭傳言”“不明烈性傳染類疾病”“美國懷疑埃及隱瞞真相”?!
偏偏沒有亞歷山大的相關新聞。難道亞歷山大只有一箱,而且被自己拿走了?
這些驚悚的信息所在地都指向埃及最富庶的尼羅河三角洲地區!他了解這種操作,要造成以一個主要地區為中心,向四周發散的效果,而且時間要先後錯開,這樣就象是自然瘟疫了。
疫情剛剛發生,任何國家都需要一個確定的過程。
真相尚未查明,如何隱瞞真相?
這無恥的邏輯只有包藏禍心者具備。
越看心越涼,出大事了。安道瞄了一眼自己的箱子,卻不經意地發現赫伊裏也在看。
(待續)
